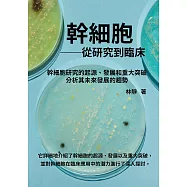
幹細胞──從研究到臨床：幹細胞研究的起源、發展和重大突破，分析其未來發展的趨勢 (電子書)

熱門搜尋
| 分類(單選) |
顯示所有篩選
|
|---|---|
| 配送方式(可複選) | |
| 上市日期(可複選) | |
| 電子書(可複選) | |
| 其他(可複選) |
搜尋結果共 839 筆, 頁數 1 / 14
- 列表
- 小圖
呈現:
(2瓶任選超值組)日本Laundrin朗德林-TOKYO植萃消臭衣物香氛柔軟精600ml/瓶(織物洗滌柔順劑,親膚蓬鬆防靜電粉塵,室內晾曬芳香護衣,手洗機洗皆適用) 優雅花香(紅)+經典花蕾(粉)各1瓶
日用
- 優惠價: 1853 元
(2瓶任選超值組)日本Laundrin朗德林-TOKYO植萃消臭衣物香氛柔軟精600ml/瓶(織物洗滌柔順劑,親膚蓬鬆防靜電粉塵,室內晾曬芳香護衣,手洗機洗皆適用) 經典花香(白)+木質花香(金)各1瓶
日用
- 優惠價: 1853 元
(2瓶任選超值組)日本Laundrin朗德林-TOKYO植萃消臭衣物香氛柔軟精600ml/瓶(織物洗滌柔順劑,親膚蓬鬆防靜電粉塵,室內晾曬芳香護衣,手洗機洗皆適用) 經典花香(白)+經典花蕾(粉)各1瓶
日用
- 優惠價: 1853 元
搜尋推薦
另外從您輸入的關鍵字中,推薦您關鍵字: 林熹 的結果(請點選看全部符合的商品)
-
108課綱 林熹老師帶你學測英文拿高分 (電子書)
優惠價: 270 元 -
108課綱 林熹老師帶你學測英文拿高分:6回試題+詳解
優惠價: 79 折, 284 元 -
古漢語常用字字典(繁體字本)(第4版)
優惠價: 414 元 -
超級鏈技術原理與實戰開發
優惠價: 87 折, 312 元 -
如花在野,一日一安
優惠價: 87 折, 365 元 -
區塊鏈導論
優惠價: 87 折, 338 元